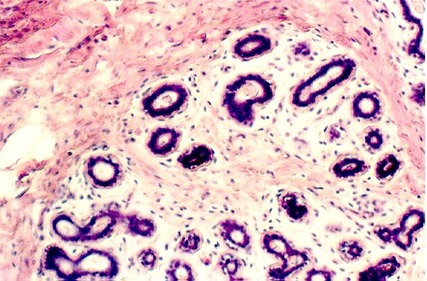

Epidermis
This is a slide of thick skin in which you have already identified the tissues in the epidermis, dermis, and hypodermis. Just for review, what tissue type is in each layer: The following photo shows a slide of thick skin. 2) Identify the layers of the epidermis on the photo.

Identify the basal layers and the stratum spinosum.
The following photographs show higher magnifications of the stratum lucidum and keratinizing layers. Identify each.

What are Langerhans' cells and where would you look for them? Review your work on the immune system. You could mark them with a labeled foreign antigen, because they are important antigen-presenting cells in the epidermis.


The above view shows the stratum spinosum, stratum granulosum, and stratum lucidum of the skin (Identify the regions). Higher magnifications are shown in the following photographs.

The stratum spinosum and granulosa are shown at higher magnification with Nomarski optics in the photo above and below this legend. The spiny appearance of the spinosum cells is caused by desmosomal attachments. The cells have shrunken away from one another and each spine represents an area where the cells are connected. Review your studies of desmosomes in the Epithelia unit.
Can you see them with 40X power (as you focus up and down) on your microscope? Also, look at the stratum granulosa cells. What is in the granules?

Thin Skin

Dermis
Identify the dermis. There are really two layers with rather indistinct boundaries. They can be distinguished by the type of connective tissue in each layer, the number of cells. The papillary layer is named because it includes the dermal papilla which are like ridges over which the epidermis lies. It is cellular and contains mostly loose connective tissue.

Thick skin, showing the epidermis and a part of the dermis. Identify the following structures: Papillary dermis, dermal papilla, epidermal pegs. Higher magnifications of these regions from your class slide set are seen in the following figure.

Region showing dermal papilla and epidermal peg.
How does the dermis serve the following functions?
Thermal Regulation
Touch
Vibration
Pain
Touch receptors are found in the dermal papillae as Meissner's corpuscles. The following views show high and low magnifications of Meissner's corpuscle in the dermis of thick skin. This is a touch receptor.


Reticular Dermis
In your slide, find the reticular layer of the dermis. The following photograph shows reticular dermis with elastic fibers (specially stained dark). This is dense, irregular connective tissue.

The hypodermis is loose connective tissue with large blood vessels, adipose tissue, nerve bundles. Sweat glands may also be found in this region. As you review this region, learn how the hypodermis performs the following functions:
a) Pressure
b) Metabolic functions
In the dermis and hypodermis, large bundles of peripheral nerves are seen. They are distinguished by a connective tissue sheath (perineurium) and nerve fasicles (bundles) that include the axons, oligodendroglia, and endoneurium.
Pacinian Corpuscles
Another receptor for Vibration is found in the hypodermis. This is
called the Pacinian Corpuscle. The following photo shows a field from the skin slide
showing peripheral nerves and two Pacinian
corpuscles. Each looks like a sliced onion.

Sweat glands
In your slide of thick skin (slide 25) identify secretory and duct portions of eccrine sweat glands. The following photographs show both portions. You should find a myoepithelial cell and classify the type of epithelium in the duct.



The ducts are distinguished by their stratified cuboidal appearance and the fact that they are much denser. Be sure you can identify ducts, glands, and myoepithelial cells in your slide set.
Hairs
Look at hair follicles in your slide of thin skin (Slide 24). Hairs are also found in the hypodermis growing up into the dermis. Each hair arises from an epidermal invagination, the hair follicle, that teminates in a dilation called the hair bulb. Find these structures in the following photographs.

At the base of a hair follicle sebaceous glands are found. These glands secrete oil, or sebum, into the follicle. They secrete via a process called "holocrine secretion" in which the cell fills with secretory material and then essentially distintegrates. In the following photographs and in your slide of thin skin find sebaceous glands.
 A
hair follicle with hair inside the shaft. In the left hand photo, 18) identify har bulb,
follicle epithelium. The dermal papilla can't be seen well, however you can find one in
your slide set. The right hand photo shows the hair going up to the epidermis. You can see
the hair follicle as an invagination of the epidermis. Another view of the follicle is
shown below.
A
hair follicle with hair inside the shaft. In the left hand photo, 18) identify har bulb,
follicle epithelium. The dermal papilla can't be seen well, however you can find one in
your slide set. The right hand photo shows the hair going up to the epidermis. You can see
the hair follicle as an invagination of the epidermis. Another view of the follicle is
shown below.

Just for fun, here are three views of hair, including straight hair, curly hair and gray hair. Note the differences in the density of the hair. It would be fun to see if "extrastrength protein conditioned hair", or "permed hair" have different densities.
Straight Hair

Curly Hair

Gray Hair

Mammary glands are essentially modified sweat glands. So many of the same structures that you studied in the above exercise will be found. However, in this exercise, we will be studying lactating and non-lactating mammary glands. You will learn to distinguish the two.
Nonlactating Mammary Gland
The following photograph shows views of non-lactating mammary gland cells. Find slides 80 and 81 in your slide set. In the non-lactating mammary gland, there is a lot of connective tissue around the glandular cells (intralobular connective tissues) and also a lot of connective tissue inbetween the lobules (interlobular connective tissue). In these photographs, use your sweat gland photos as a guide. Identify the mammary gland cells and the myoepithelial cells


Non-lactating mammary glands. Note the extensive connective tissue inside the lobules. Identify gland cells and myoepithelial cells.
Lactating mammary glands
Lactating mammary glands show spaces that are filled up with the glands themselves. Myoepithelial cells are still present and very important to aid expulsion of milk into the ducts. What hormone stimulates myoepithelial cells in the mammary gland?
Lactating mammary glands show little intralobular connective tissue and much glandular tissue. Can you find myoepithelial cells in the higher magnification view or in your slide? They may be difficult to find.


Slide 79 shows a section of the nipple. This region demonstrates stratified squamous epithelium, and a dermis that contains large bundles of smooth muscle. These stand out from the connective tissue. Also you can identify large lactiferous sinuses lined with stratified cuboidal epithelium. Be able to find these on your slide.

This section is through the dermis of the skin over the nipple of the breast. There are bundles of smooth muscle (lighter staining) running in the dense pink stained connective tissue. Large lactiferous sinuses can be found in the slide with the section of the nipple. These are lined with stratified cuboidal epithelium and are the culmination of lactiferous ducts that originate from mammary gland ducts.
URL Address: http://microanatomy.net/skin/skin_and_mammary_gland.htm
Gwen V. Childs, Ph.D., FAAA
Department of Neurobiology and Developmental Sciences
University of Arkansas for Medical Sciences
4301 W. Markham, Slot 510, Little Rock, AR 72205
For questions or concerns, send email to this address